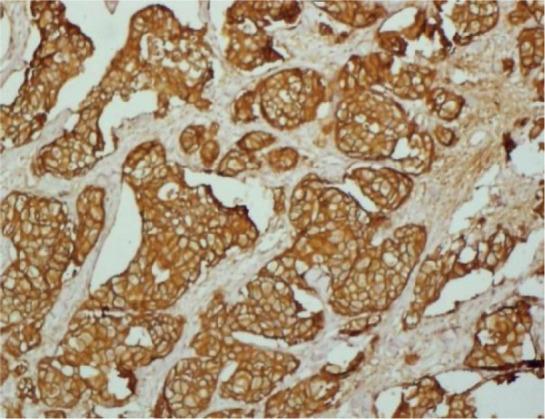

尼日利亚伊巴丹宫颈癌患者的表皮生长因子受体(EGFR)和人表皮生长因子受体2(HER2)表达情况
EGFR and HER2 expression in cervical cancer patients in Ibadan, Nigeria.
作者信息
Orekoya Ajibike Ayomide, Abdus-Salam Abbas A, Oyesegun Abdurasaq R, Ntekim Atara I, Folasire Ayorinde M, Okolo Clement A, Olabumuyi Adeniyi A, Dada Adedamola A, Adenipekun Adeniyi A
机构信息
Federal Medical Centre Ebute-Metta, Lagos 101211, Lagos State, Nigeria.
Radiation Oncology Department, University College Hospital, Ibadan 200212, Oyo State, Nigeria.
出版信息
Ecancermedicalscience. 2023 Oct 2;17:1607. doi: 10.3332/ecancer.2023.1607. eCollection 2023.
Cervical cancer is a leading cause of cancer-related deaths in developing countries, including Nigeria where it is the second most common female malignancy. Studies from elsewhere have demonstrated the relationship between epidermal growth factor receptor (EGFR) and human epidermal growth factor receptor 2 (HER2) and advanced cervical cancer. However, we are not aware of such studies in Nigerian patients. The main objective of the study was to determine the prevalence of EGFR or HER1 and HER2 protein expression in cervical cancers and to determine their impact on overall survival. Clinical data and formalin-embedded tissue blocks of 124 patients who presented in the Radiation Oncology Department, University College Hospital (UCH), from 2006 to 2015 and had their histological diagnosis at the Pathology Department, UCH were retrieved and analysed for EGFR and HER2 expression using immunohistochemistry. EGFR expression was analysed using the immunoreactivity score by Remmele and Stegner. HER2 was analysed using the Hercep® test kit guidelines. Survival analysis was done using Kaplan-Meier and Cox regression analysis. Missing data were reported as missing, not documented. EGFR (immunoreactivity score > 4) was overexpressed in 26.6% of the 124 cervical tissue samples tested. Most patients whose samples were positive for EGFR were young, had squamous cell carcinoma and advanced diseases. HER2 was overexpressed in two samples (1.6%). The 5-year overall survival rate of the patients was 28.3%. The 5-year survival rate of patients who were EGFR positive was 9.5% and 34.1% for those who were EGFR negative. Screening for EGFR should be considered in cervical cancer patients. HER2 was overexpressed in two cervical tissue samples in this study and may be of poor interest as a potential target in the management of cervical cancer patients. Large prospective multi-institutional studies should be considered to further explore the relationship between EGFR and survival in cervical cancer patients.
宫颈癌是包括尼日利亚在内的发展中国家癌症相关死亡的主要原因,在尼日利亚,宫颈癌是第二常见的女性恶性肿瘤。其他地方的研究已经证明表皮生长因子受体(EGFR)和人表皮生长因子受体2(HER2)与晚期宫颈癌之间的关系。然而,我们并不了解尼日利亚患者的此类研究情况。该研究的主要目的是确定宫颈癌中EGFR或HER1和HER2蛋白表达的患病率,并确定它们对总生存期的影响。检索了2006年至2015年在大学学院医院(UCH)放射肿瘤科就诊并在UCH病理科进行组织学诊断的124例患者的临床数据和福尔马林固定组织块,采用免疫组织化学方法分析EGFR和HER2的表达。使用Remmele和Stegner的免疫反应性评分分析EGFR表达。使用Hercep®检测试剂盒指南分析HER2。采用Kaplan-Meier法和Cox回归分析进行生存分析。缺失数据报告为缺失,未记录。在检测的124份宫颈组织样本中,26.6%的样本EGFR(免疫反应性评分>4)过度表达。大多数EGFR样本阳性的患者为年轻女性,患有鳞状细胞癌且病情处于晚期。HER2在两个样本(1。6%)中过度表达。患者的5年总生存率为28.3%。EGFR阳性患者的5年生存率为9.5%,EGFR阴性患者为34.1%。宫颈癌患者应考虑进行EGFR筛查。本研究中有两个宫颈组织样本HER2过度表达,作为宫颈癌患者管理的潜在靶点可能意义不大。应考虑开展大型前瞻性多机构研究,以进一步探索EGFR与宫颈癌患者生存之间的关系。